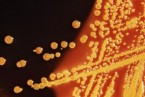

Botánica
Investigadoras argentinas descubren unos compuestos que protegen a las plantas de la radiación ultravioleta
Investigadoras del Centro de Estudios Fotosintéticos y Bioquímicos, dependiente del CONICET y de la Universidad Nacional de Rosario, ambos en Argentina, descubrieron que unos compuestos presentes en los vegetales llamados flavonoles los protegen de la radiación ultravioleta. Los resultados de esta investigación se publicaron recientemente en la revista Molecular Plant.
La becaria Julia Emiliani, las doctoras Paula Casati y Lorena Falcone Ferreyra llevaron adelante una serie de estudios que permitieron comprobar el efecto fotoprotector de los flavonoles. Este proyecto se realizó en colaboración con el laboratorio de la Universidad Estatal de Ohio (OSU) dirigido por el doctor Erich Groteworld.
“Los flavonoles cumplirían una función similar a la que llevan a cabo los protectores solares en los humanos”, explica Casati y agrega “por esto se acumulan principalmente en la epidermis de la planta”.
Las investigadoras obtuvieron en el laboratorio plantas de arabidopsis –una especie modelo- capaces de producir mayor cantidad de flavonoles gracias a la introducción de un gen de maíz que genera la enzima flavonol sintasa. “La planta, además de tener su propia enzima, tiene la del maíz que le introdujimos y, como consecuencia, sintetiza mayores niveles de flavonoles”, señala Emiliani. ![[Img #13204]](upload/img/periodico/img_13204.jpg)
Estas plantas transgénicas fueron expuestas junto con otras sin modificar a una radiación UV similar a la que produce el sol al mediodía en el verano. Luego las investigadoras las compararon entre sí y observaron que aquellas plantas con más flavonoles habían sufrido menor daño en las membranas biológicas, los fotosistemas, la clorofila y el ADN.
Esta investigación se enmarca en un proyecto más amplio que comprende el estudio de la familia de los flavonoides: un conjunto de compuestos que cumple un papel regulador dentro de los vegetales y a los cuales, según indica Casati, se le han atribuido funciones, por ejemplo: antioxidante y anticancerígena, que en algunos casos no están probadas.
En esta línea, el grupo de investigación local, en colaboración con el de la Universidad Estatal de Ohio, busca caracterizar los genes que le permiten a las plantas producir flavonoides y probar cuál es el rol de cada uno de estos compuestos.
El proyecto cuenta con financiación de la Agencia Nacional de Promoción Científica y Técnica dentro del programa Raíces y del CONICET a través de un subsidio de Cooperación Internacional. (Fuente: CONICET/DICYT)